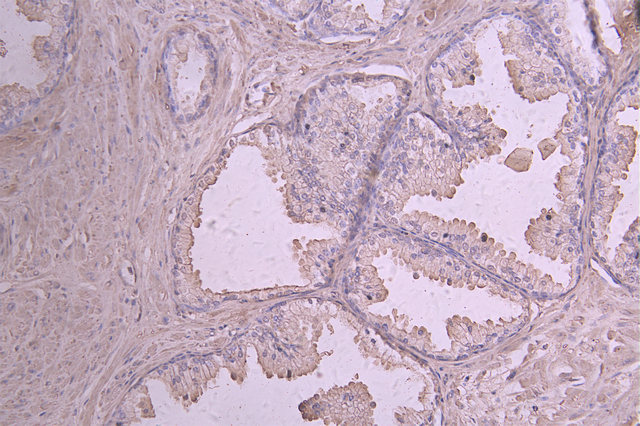

IL12A Recombinant Monoclonal Antibody
-
中文名稱:IL12A (briakinumab) Recombinant Monoclonal Antibody
-
貨號:CSB-RA011586MA1HU
-
規(guī)格:¥1320
-
圖片:
-
IHC image of CSB-RA011586MA1HU diluted at 1:50 and staining in paraffin-embedded human prostate cancer performed on a Leica BondTM system. After dewaxing and hydration, antigen retrieval was mediated by high pressure in a citrate buffer (pH 6.0). Section was blocked with 10% normal goat serum 30min at RT. Then primary antibody (1% BSA) was incubated at 4°C overnight. The primary is detected by a Goat anti-human polymer IgG labeled by HRP and visualized using 0.05% DAB.
-
Overlay Peak curve showing HEK293 cells stained with CSB-RA011586MA1HU (red line) at 1:100. The cells were fixed in 4% formaldehyde and permeated by 0.2% TritonX-100 for 10min. Then 10% normal goat serum to block non-specific protein-protein interactions followed by the antibody (1ug/1*106cells) for 45min at 4℃. The secondary antibody used was Fluorescein (FITC) AffiniPure Goat Anti-Human IgG, Fcγ fragment specific at 1:200 dilution for 35min at 4℃.Control antibody (green line) was human IgG1 (1ug/1*106cells) used under the same conditions. Acquisition of >10,000 events was performed.
-
-
其他:
產(chǎn)品詳情
-
Uniprot No.:
-
基因名:
-
別名:CLMF antibody; CLMF p35 antibody; CLMF p40 antibody; CLMF1 antibody; CLMF2 antibody; Cytotoxic lymphocyte maturation factor 1, p35 antibody; Cytotoxic lymphocyte maturation factor 2 antibody; Cytotoxic lymphocyte maturation factor 35 kDa subunit antibody; Cytotoxic lymphocyte maturation factor 40 kDa subunit antibody; IL 12A antibody; IL 2 subunit p40 antibody; IL-12 subunit p35 antibody; IL-12A antibody; IL-12B antibody; IL12 antibody; IL12, p35 subunit antibody; IL12, subunit p40 antibody; IL12A antibody; IL12A_HUMAN antibody; IL12B antibody; IL35 subunit antibody; Interleukin 12 alpha chain antibody; Interleukin 12 beta chain antibody; Interleukin 12 subunit beta antibody; Interleukin 12, p40 antibody; Interleukin 12A (natural killer cell stimulatory factor 1, cytotoxic lymphocyte maturation factor 1, p35) antibody; Interleukin 12B (natural killer cell stimulatory factor 2, cytotoxic lymphocyte maturation factor 2, p40) antibody; Interleukin 12B antibody; Interleukin-12 subunit alpha antibody; Natural killer cell stimulatory factor 1, 35 kD subunit antibody; natural killer cell stimulatory factor 2 antibody; Natural killer cell stimulatory factor, 40 kD subunit antibody; NF cell stimulatory factor chain 1 antibody; NFSK antibody; NK cell stimulatory factor chain 1 antibody; NK cell stimulatory factor chain 2 antibody; NKSF antibody; NKSF1 antibody; NKSF2 antibody; P35 antibody
-
反應(yīng)種屬:Human
-
免疫原:Recombinant Human IL12A protein
-
免疫原種屬:Homo sapiens (Human)
-
標(biāo)記方式:Non-conjugated
-
克隆類型:Monoclonal
-
抗體亞型:hIgG1
-
純化方式:Affinity-chromatography
-
克隆號:4D6
-
濃度:It differs from different batches. Please contact us to confirm it.
-
保存緩沖液:Preservative: 0.03% Proclin 300
Constituents: 50% Glycerol, 0.01M PBS, PH 7.4 -
產(chǎn)品提供形式:Liquid
-
應(yīng)用范圍:ELISA, IHC, FC
-
推薦稀釋比:
Application Recommended Dilution IHC 1:50-1:200 FC 1:50-1:200 -
Protocols:
-
儲存條件:Upon receipt, store at -20°C or -80°C. Avoid repeated freeze.
-
貨期:Basically, we can dispatch the products out in 1-3 working days after receiving your orders. Delivery time maybe differs from different purchasing way or location, please kindly consult your local distributors for specific delivery time.
-
用途:For Research Use Only. Not for use in diagnostic or therapeutic procedures.
相關(guān)產(chǎn)品
靶點(diǎn)詳情
-
功能:Cytokine that can act as a growth factor for activated T and NK cells, enhance the lytic activity of NK/lymphokine-activated killer cells, and stimulate the production of IFN-gamma by resting PBMC.
-
基因功能參考文獻(xiàn):
- These results suggest that IL-12A rs568408 may contribute to the etiology and symptoms severity of asthma, indicating its usefulness as a predictive and diagnostic biomarker of asthma. PMID: 28600552
- Study provides evidence that the AA genotype of IL-12A rs568408 is associated with an increased lung cancer risk among Taiwanese, especially those with smoking habits. PMID: 30396953
- IL-35 may have a role in renal involvement in lupus nephritis patients PMID: 29576585
- The IL-35 levels in CagA(+) H. pylori-infected participants from peptic ulcer and H. pylori-infected asymptomatic groups were lower than individuals infected with CagA(-) strains. PMID: 29938865
- these data demonstrate the expression of IL35 in oral lichen planus lesions PMID: 29633015
- IL-12 receptor signalling in keratinocytes initiates a protective transcriptional programme that limits skin inflammation. PMID: 27892456
- The present study investigated the relationship of IL35 in patients with immunorelated hemocytopenia (IRH). Serum level of IL35 was decreased in untreated patients with IRH compared with remission patients (P<0.01) and was significantly associated with clinical indexes. PMID: 29257310
- IL-35 may be involved in the pathogenesis of Primary biliary cirrhosis. PMID: 29445068
- The overall results showed that cancer risk was increased by IL-12A rs568408 (GG versus GA + AA: P = 0.004; G versus A: P = 0.005) and IL-12B rs3212227 (AA versus AC + CC: P = 0.004; CC versus AA + AC: P = 0.03; A versus C: P = 0.007) polymorphisms. However, we failed to detect any significant associations between the IL-12A rs2243115 polymorphism and cancer risk in either the overall or the subgroup analyses. PMID: 28408727
- IL-35 is a relatively newly discovered member of the IL-12 family which are unique in structure as they are dimer formed by two subunits; recent findings have shown abnormal expression of IL-35 in inflammatory autoimmune diseases and functional analysis suggested that IL-35 is critical in the onset and development of these diseases. [Review] PMID: 29729445
- The results suggest IL12A genotype predict higher risk of death and progression, respectively, in NSCLC patients. PMID: 28807247
- IL-35 expression was significantly increased in patients with chronic hepatitis C and was positively correlated with the levels of viral RNA PMID: 28644966
- Pancreatic ductal carcinoma cells produce IL35 to recruit monocytes via CCL5 and induce macrophage to promote angiogenesis via expression of CXCL1 and CXCL8. PMID: 28989066
- Polymorphisms of IFNL3 rs8099917 and IL12A rs568408 contribute to survival of HD patients, but not as independent factors. PMID: 28525983
- The anti-EGFR viroplexes with IL-12 and salmosin genes exhibited the most effective therapeutic efficacy in a mouse tumor model, especially when combined with doxorubicin. PMID: 27191929
- baseline serum IL-12 levels were significantly higher in those pediatric hematopoietic stem cell transplantation recipients who did not develop acute graft versus host disease PMID: 27751764
- Our data indicated that decreased expression of IL-35 in tumor tissues might contribute to the progression of hepatocellular carcinoma PMID: 27329841
- circulating mir-21 and expression of the IL-12p35 gene were observed significantly downregulated in current smokers with CAD. PMID: 27765464
- Simultaneous elevated circulating levels of IL-18 and IL-12 increased the event rate after 2 years in Coronary Artery Disease patients, independent of hyperglycemia PMID: 27058587
- The study revealed that post-therapeutic recovery of circulating IL-35 concentration might be an independent predictor for effective response to IST in pediatric AA. PMID: 28211781
- Epstein Barr Virus miRNAs collectively and specifically suppress release of proinflammatory cytokines such as IL-12, repress differentiation of naive CD4(+) T cells to Th1 cells. PMID: 27621419
- assembly-induced folding is key in IL-12 family biogenesis and secretion; the identification of essential disulfide bonds that underlie this process lays the basis for a simplified yet functional IL-12 cytokine PMID: 28325840
- The plasma levels of interleukin-35 were significantly higher in the hepatocellular carcinoma patients than the controls. PMID: 27699510
- Importantly, treatment of NK cells from HIV-infected patients with IL-12 reversed the multiple defects in binding, granule polarization, perforin content, and perforin release and restored anticryptococcal activity. PMID: 27555306
- The results of this case-control study suggest that IL-12A, IL-12B, IL12RB1, IL12RB2 and IL23R make no genetic contribution to the susceptibility of Takayasu arteritis in Chinese populations PMID: 26987707
- this study introduces IL-35 as a new treatment for pemphigus PMID: 27855302
- suberoylanilide hydroxamic acid significantly inhibited IL-12p40 and IL-23p19 mRNA synthesis and did not change IL-12p35 mRNA transcription. PMID: 27240992
- this study shows that IL-12A gene polymorphism contributes to the risk of hepatocellular carcinoma on top of chronic hepatitis C virus infection in Egyptian patients PMID: 27819525
- The results suggest that hepatocellular carcinoma (HCC). cell apoptosis was suppressed at least partially through HBx-induced miR-21 by targeting IL-12. PMID: 27571873
- These data indicate that increased serum IL-35 could act as a disease activity marker and as a risk factor for esophageal involvement in idiopathic inflammatory myopathies. PMID: 27502600
- The results of Expression Quantitative Trait Loci analysis showed that the risk alleles of rs4679868 and rs6441286 were significantly associated with decreased expression of IL12A in lymphoblastoid cell lines derived from individuals of Chinese Han ancestry. These results demonstrated that IL12A is associated with Primary Biliary Cirrhosis in the Chinese Han population. PMID: 27175695
- The highest gene transfer ability was achieved by the DTPA-conjugated PEI at the conjugation degree of 0.1 % where the level of IL-12 production increased up to twofold compared with that of the unmodified PEI PMID: 26801817
- TLR3 is required to induce full IL-12p70 secretion. PMID: 26956584
- Interleukin-12 A rs17810546 was positively associated with celiac disease. PMID: 27043536
- Data show that interleukin-35 (Epstein-Barr virus-induced gene 3 (EBI3) and the interleukin-12 Subunit p35 (p35) subunit) levels were significantly elevated in the patients with influenza infection. PMID: 26844658
- the functional single nucleotide polymorphism IL-12A rs2243115 GG genotype may increase the risk of rheumatoid arthritis in rheumatoid factor negative patients PMID: 26375522
- Low IL12 expression levels are associated with Acute Leukemia. PMID: 26514528
- Study indicated that the rs568408 variation in IL-12A gene could influence disease susceptibility, and was associated with the severity of oral lichen planus in our East Chinese cohort. PMID: 25258182
- These results for the first time demonstrate a role of Cdk5/p35 in the regulation of cell cycle progression modulated by TGF-beta1. PMID: 26966064
- IL-35 was elevated in bone marrow of adult AML patients and this increase was correlated with the clinical stages of malignancy, suggesting that IL-35 is involved in pathogenesis of AML. PMID: 26431888
- p41 fragment is also shown to reduce the secretion of interleukin-12 (IL-12/p70) during the subsequent maturation of treated dendritic cells. PMID: 26960148
- IL-35 plays a protective role in the pathogenesis of rheumatoid arthritis PMID: 26370008
- Findings demonstrate that IL-12 is increased significantly in chronic hepatitis B patients and that viral protein HBx induces IL-12 expression in hepatocytes through the activation of the PI3K/Akt pathway. PMID: 26062743
- Serum levels of IL-35 increased in normal pregnancy and decreased in recurrent spontaneous abortion. PMID: 26042836
- IL-35 Is Involved in the Pathogenesis of Guillain-Barre Syndrome Through Its Influence on the Function of CD4+ T Cells PMID: 26225474
- Elevated circulating IL-35, particularly at early phase, its decrease after treatment initiation, and a positive association between synovial fluid IL-35 and disease activity support an involvement of IL-35 in the pathogenesis of RA. PMID: 26204444
- Gene-gene interaction analysis showed that subjects carrying the IL-12A rs568408AG/AA and IL-12B rs3212227AA genotypes had a 2.40-fold increased risk of CRC (OR = 2.40; 95 % CI, 1.14-5.07) PMID: 26104769
- the distribution of interleukin (IL)-12 (IL12; 1188A/C), IL17 (A7488G) and IL-23 receptor (IL23R; +2199A/C) gene polymorphisms in patients with alopecia areata, was investigated. PMID: 26017027
- Genome-wide association study in an admixed case series reveals IL12A as a new candidate in Behcet disease PMID: 25799145
- These results might indicate an important new role for IL-35 as an autocrine growth factor in pancreatic cancer growth. PMID: 25073578
顯示更多
收起更多
-
亞細(xì)胞定位:Secreted.
-
蛋白家族:IL-6 superfamily
-
數(shù)據(jù)庫鏈接:
Most popular with customers
-
-
YWHAB Recombinant Monoclonal Antibody
Applications: ELISA, WB, IHC, IF, FC
Species Reactivity: Human, Mouse, Rat
-
-
-
-
-
-
VDAC1 Recombinant Monoclonal Antibody
Applications: ELISA, WB, IHC
Species Reactivity: Human, Mouse, Rat